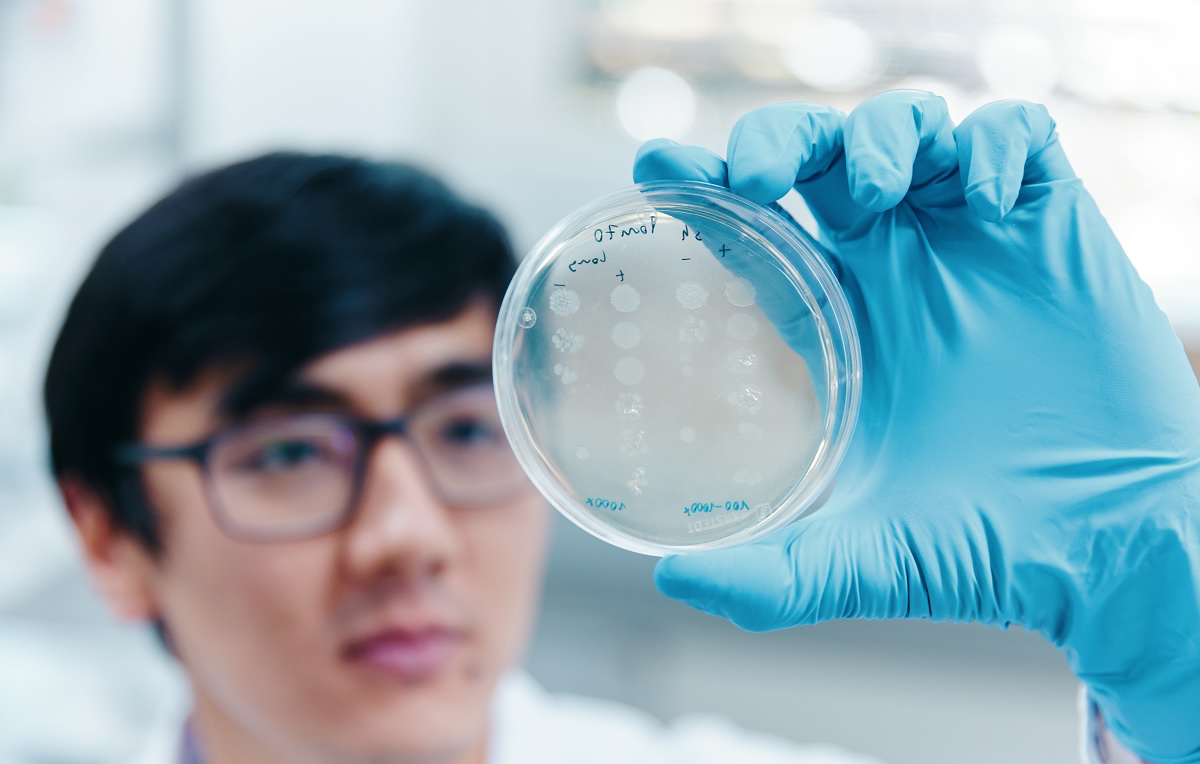

Қазақстандық ғалым соқырлықты емдеудің жаңа жолын тапты
 Сурет авторы: предоставлено Институтом молекулярной и клинической офтальмологии Базеля (IOB)
Сурет авторы: предоставлено Институтом молекулярной и клинической офтальмологии Базеля (IOB)
Базель университетінің (Швейцария) докторанты, 27 жастағы қазақстандық нейробиолог Темурхан Аюповтың жетекшілігімен жүргізілген ғылыми зерттеу әлемдегі ең беделді «Nature» журналында жарияланды. Ғалымдар тобы глаукома мен Паркинсон сияқты нейродегенеративті ауруларды емдеуде төңкеріс жасайтын жаңа әдісті таныстырды.
Зерттеудің негізгі нысаны — жасушаның басты энергия көзі болып табылатын митохондриялар. Глаукома мен Паркинсон аурулары кезінде жүйке жасушалары мен көз торының аксондары митохондриялардың зақымдануы салдарынан энергия тапшылығына ұшырап, біртіндеп жойыла бастайды.

Темурхан Аюпов пен оның командасы зақымдалған жасушаларға сау митохондрияларды нысаналы түрде жеткізуге мүмкіндік беретін MitoCatch технологиясын ойлап тапты. Бұл әдісті ғалымдар бейнелі түрде «митохондриялық GPS жүйесі» деп атайды.
Бұған дейін қолданылған донорлық митохондрияларды тасымалдау әдістерінің тиімділігі төмен болатын. Жаңа технология бойынша:
• Донорлық митохондриялардың бетіне нысаналы жасушаларды танитын арнайы ақуыздық маркерлер қосылады.
• Бұл молекулалар зақымдалған жасушалардың рецепторларымен байланысып, митохондрияның нақты адресатқа жетуін қамтамасыз етеді.
• Байланыс орнағаннан кейін жасуша сау митохондрияны ішке тартып, оны жаңа қуат көзі ретінде пайдаланады.
Алты жылға созылған зерттеу барысында 17 елден жиналған 29 ғалым 50-ден астам қосымша эксперимент жүргізді. Тәжірибелер Лебер ауруына (көз жанарының тұқым қуалайтын жоғалуы) шалдыққан науқастардың нейрондарына және зертханалық тышқандарға жүргізілген.
Зерттеу қорытындысы бойынша:
• Материалды жеткізу дәлдігі 1000%-дан астамға артты.
• Адам нейрондарының тіршілік ету қабілеті 23,6%-ға, ал тышқандарда 40%-ға жақсарды.
Қазіргі уақытта ғылыми жоба негізінде биотехнологиялық стартап құрылуда. Темурхан Аюпов бастаған команда технологияны практикалық медицинаға енгізу және алғашқы клиникалық сынақтарды өткізу үшін 20 миллион АҚШ доллары көлемінде инвестиция тартуды көздеп отыр.
«Nature» журналындағы жарияланым бұл технологияның халықаралық деңгейде мойындалуын және ірі фармацевтикалық компаниялар тарапынан сенімділіктің артуын қамтамасыз етеді. Бұл жаңалық болашақта соқырлық пен ауыр нейронологиялық дерттерді емдеудің баламасыз әдісіне айналуы мүмкін.

Соңғы жаңалықтар
-
Алакөлде «Алакөл алаулары – 2026» фестивалімен жаңа туристік маусым ашылды
15 сағат бұрын
-
Қошанов Польша Сенатының Маршалымен екіжақты байланысты талқылады
1 күн бұрын
-
МӘЖІЛІС ТӨРАҒАСЫ ЧЕРНОГОРИЯ ПРЕЗИДЕНТІМЕН КЕЗДЕСТІ
1 күн бұрын
-
Димаш Құдайберген Шығыс Қазақстандағы халықаралық этникалық фестивальдің басты қонағы болады
1 күн бұрын
-
Абай облысында камера қателігінен салынған 172 айыппұл жойылды
1 күн бұрын
-
Астанада «GovHR Forum-2026» халықаралық форумы өтті: Мемлекеттік басқарудағы жаңашылдықтар талқыланды
1 күн бұрын
-
Ұлттық экономика министрлігі QR-төлемдер мен аударымдарға қатысты салықтық режим туралы түсініктеме берді
1 күн бұрын
-
Қазақстанда мұғалімдерді аттестаттаудың жаңа жүйесі енгізіледі
2 күн бұрын
-
Вьетнамға баратындарға ескерту: шекарадан өту тәртібі өзгерді
2 күн бұрын
-
Астанада GovHR Forum-2026 халықаралық форумы өтті: Қазақстанның мемлекеттік басқарудағы жаңа бастамалары
2 күн бұрын
-
Мәжіліс депутаттары шетелдік мамандармен сайлау заңнамасын жетілдіру мәселелерін талқылады
2 күн бұрын
-
ЖОО-ларға қабылдау басталды: талапкерлерге арналған маңызды ақпарат
2 күн бұрын
-
Атырау әкімдігінің шенеуніктері жеке меншік мектептің құрылысына бөгет болғаны үшін жазаға тартылды
2 күн бұрын
-
Ресей аймақтарында әуе қорғанысы 555 дронды атып түсіргені хабарланды
2 күн бұрын
-
АҚШ-та Қазақстан азаматы ұсталды: СІМ жағдайды бақылап отыр
2 күн бұрын
-
Қазақстанда ең қымбат саналатын «Хейлибери» мектептері тарихта қалмақ
2 күн бұрын
-
Денсаулық сақтау министрлігі еліміздің үздік перзентханалары мен балалар ауруханаларын анықтады
2 күн бұрын
-
Астаналық түлектер мектеп бітіру кешін қайырымдылық акциясына арнады
2 күн бұрын
-
Астанада мектептер мен индустриялық парк салу үшін 50-ден астам жер учаскелері алынады
2 күн бұрын
-
JET самокаттарын пайдалануға жаңа талаптар енгізіледі
2 күн бұрын
-
111 талапкерді грантқа түсіремін деп 70 млн тг жинаған алаяқ 4 жылға сотталды
3 күн бұрын
-
Черногория Президенті Қазақстанға ресми сапармен келеді
3 күн бұрын
-
Үкімет резервінен спортшылар мен жаттықтырушыларға сыйақы төленді
3 күн бұрын
-
Цифрлық технологияның арқасында диагностика жасау уақыты төрт есеге қысқарды – Тоқаев
3 күн бұрын
-
Тоқаев: Ұлт саулығы – еліміз үшін бәрінен қымбат құндылық
3 күн бұрын
-
eGov Mobile-да газ көрсеткіштерін жолдаудың жаңа тәсілі іске қосылды
3 күн бұрын
-
Төреғали Төреәлі Дастан Сәтбаевқа арналған жаңа әнін таныстырды
3 күн бұрын
-
Өзбекстанның тарихи голы тіркелді, бірақ жеңіс бұйырмады
3 күн бұрын
-
Өскеменде үш жасар бүлдіршін үйінен 1,5 шақырым жерден табылды
3 күн бұрын
-
Сенат депутаты «Жайлы мектеп» жобасын жүзеге асырудағы қаржылық тиімсіздікке қатысты мәселені көтерді
3 күн бұрын
-
Мәулен Әшімбаев отандық бизнестің мемлекеттік қаржыландыруға тәуелділігіне алаңдаушылық білдірді
3 күн бұрын
-
Денсаулық сақтау министрлігі 2027 жылға қарай стационарлық емдеуге жатқызу көрсеткішін 20%-ға төмендетуді жоспарлап отыр
3 күн бұрын
-
Apple өнімдері қымбаттайды: Тим Кук бағаның өсуін растады
3 күн бұрын
-
Қазақстанда барлық банкке ортақ бірыңғай QR-төлем жүйесі іске қосылады
3 күн бұрын
-
Таиланд визасыз жүру мерзімін 30 күнге дейін қысқартты: туристер үшін қандай өзгерістер бар
3 күн бұрын
-
Қырғызстанда балаға әкесі мен анасының тегін қатар беру мәселесі қарастырылуда
3 күн бұрын
-
Алматыда Саин көшесінде қоғамдық көлікке арналған арнайы жолақ іске қосылады
3 күн бұрын
-
Ашығу режимі миды стресстен қалай қорғайды
3 күн бұрын
-
Синоптиктер ескертеді: Қазақстанның үш ірі қаласында қолайсыз ауа райы күтілуде
3 күн бұрын
-
Маңғыстау облысында еңбек нарығы өзгеруде: Сұраныс қай салаларға ауды
3 күн бұрын
-
Түркістан облысының әкімі «Дара ұрпақ» инклюзивті театрының ұжымымен кездесті
3 күн бұрын
-
2026 жылғы білім беру гранттарына құжат қабылдау мерзімі белгіленді
3 күн бұрын
-
Астанада Мәңгілік Ел даңғылы мен Сығанақ көшесінің қиылысында қозғалыс жартылай шектелді
3 күн бұрын
-
Астанада саябақты өртеген жасөспірімдер анықталды
4 күн бұрын
-
Алматы облысында сушиден 19 адам уланды: тамақтану орнында санитарлық тексеріс басталды
4 күн бұрын
-
Иран Қазақстанға Парсы шығанағындағы маңызды порттардың бірінен арнайы жер телімін бермек
4 күн бұрын
-
Қазақстанның барлық казармаларында «ақылды» бейнебақылау жүйелері орнатылады
4 күн бұрын
-
Мәжіліс депутаты Ә. Мүтәлі сейсмикалық қауіпсіздік жүйесін цифрландыруды талап етті
4 күн бұрын
-
Депутат «Батыс Еуропа – Батыс Қытай» күре жолындағы жылдамдық режимін қайта қарауды талап етті
4 күн бұрын
-
«AMANAT» фракциясы шетелдік қаржыландыруды бақылауды күшейтуді ұсынады
4 күн бұрын